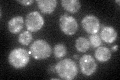
YEL015W

View description
Non-essential conserved protein of unknown function, plays a role in mRNA decapping by specifically affecting the function of the decapping enzyme Dcp1p; localizes to cytoplasmic mRNA processing bodies
Localization:
Intensity:
Fold change:
Significance:
-
C’ GFP library in SD
punctate44.03 -
N' NOP1pr-GFP in SD

punctate97.2898 -
N' TEF2pr-mCherry in SD

nucleus127.94 -
N' NATIVEpr-GFP in SD

punctate45.2606 -
N' TEF2pr-VC and Cyto-VN in SD

#N/A0 -
C’ GFP library in SD+DTT

punctate44.521.01No -
C’ GFP library in SD+H2O2

punctate51.271.16No -
C’ GFP library in Starvation Media

punctateN/AN/AYes -
C’ GFP library on the background of Pup2-DaMP

punctate -
C’ GFP library on the background of CCT mutant

punctate48.24641.09571No
